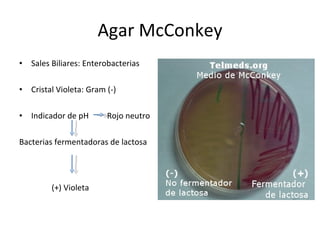
Agar McConkey Sales Biliares: Enterobacterias Cristal Violeta: Gram (-) Indicador de pH  Rojo neutro Bacterias fermentadoras de lactosa (+) Violeta

Este documento describe una serie de pruebas bioquímicas para caracterizar microorganismos (MO), incluyendo pruebas relacionadas con la respiración celular, fuente de carbono, compuestos nitrogenados, y pruebas IMViC para diferenciar bacterias entéricas. Explica procedimientos como la prueba de la catalasa, agar hierro de Kliger, ureasa, indol, rojo metilo, Voges Proskauer y citrato.